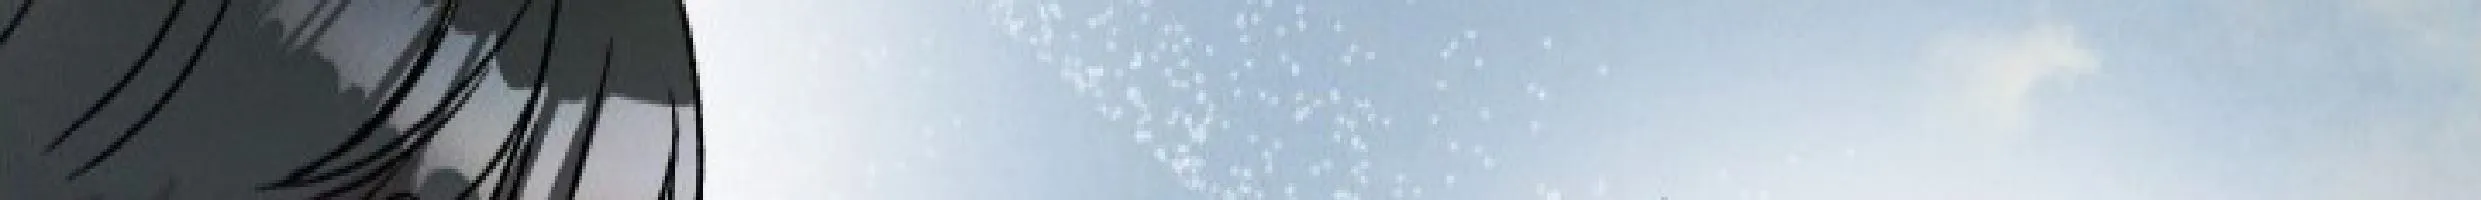

بلاغات
⚠️ إرسال بلاغ عن هذا الفصل
اختر نوع البلاغ:
نوع خطأ الفصل:
نوع مشكلة الترجمة:
ترجمة غير دقيقة - في أي جزء تحديداً؟
أخطاء إملائية/نحوية - في أي جزء تحديداً؟
تنسيق/تحرير النص سيء - في أي جزء تحديداً؟
أجزاء غير مترجمة - في أي جزء تحديداً؟
نوع مشكلة الموقع:
مشكلة في التسجيل/الدخول - يمكنك تقديم تفاصيل أكثر؟
مشكلة أمنية - يمكنك تقديم تفاصيل أكثر؟
مشكلة أخرى - يمكنك تقديم تفاصيل أكثر؟
نوع انتهاك حقوق النشر:
هذا الفصل من حقك - يمكنك تقديم تفاصيل أكثر؟
هذا الفصل من حق غيرك - يمكنك تقديم تفاصيل أكثر؟
قام طرف آخر بسرقة هذا الفصل - يمكنك تقديم تفاصيل أكثر؟
مراجعة البلاغ قبل الإرسال:
نوع البلاغ:
النوع الفرعي:
التفاصيل:
البريد الإلكتروني:
رابط الفصل:
https://peach-bl.com/chapter/%d9%85%d9%87%d8%af-%d8%ad%d9%88%d8%b1%d9%8a%d8%a9-%d8%a7%d9%84%d8%a8%d8%ad%d8%b1-%d8%a7%d9%84%d9%81%d8%b5%d9%84-5/
✅
تم إرسال البلاغ بنجاح!
شكراً لك على المساعدة في تحسين الموقع. سيتم مراجعة بلاغك والرد عليك قريباً.
الإعدادات
أسلوب القراءة
عمودي
صفحة واحدة
صفحتان
إعدادات أخرى
اتجاه القراءة
من اليمين لليسار
من اليسار لليمين
التعليقات